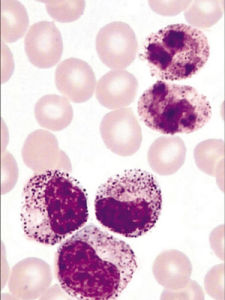
肛周炎 肛周炎

病因
肛周炎是產生與出汗過多、衛生狀況差、磨擦、搔抓、外傷等一種大汗腺的化膿性細菌感染性疾病初起形成皮下結節,化膿破潰後形成局部潰瘍,最終疤痕癒合。多發於中青年人群,在對肛周炎的的診斷中,其臨床症狀中最顯著的特點是結節潰瘍,有的肛周炎症狀嚴重甚至形成瘺管。肛周炎的發病初期會出現單個的或者數個豌豆大小的皮下結節,局部呈半球狀隆起,可增大至胡桃大,紅腫疼痛,全身症狀輕微,經數周或數月結節軟化,深部化膿,破潰後形成潰瘍。也有纏綿日久呈慢性過程,或形成廣泛瘺道。
治療
肛周炎1、紅黴素或四環素類。
2、強的松或強的松龍。
3、肛周爽護理劑,對金黃色葡萄球菌,大腸桿菌效果明顯。
4、有瘺管者需手術治療
有個民間的小驗方:取豬苦膽一個剪破流出膽汁,再加入紅糖3克、冰片2克,放入鐵鍋內,用火爐文火熬至如膏狀。用時剪消毒紗布,重疊三層,塗上膏藥,敷肛門,外用膠布固定,大便時取出,每日換藥二次,三天左右可治癒
引起肛門癢的可能原因:
1、心理因素
有壓力或焦慮時、懷疑自身恐患有肛門腫瘤時(即疑病症)。
2、全身系統性疾病或皮膚病
濕疹、糖尿病、念珠菌感染、蟯蟲感染、股癬、乾癬、腹瀉造成脫皮、抗生素之使用。
3、局部肛門直腸病變.
肛周炎4、過份注重肛門局部衛生
5、接觸性皮膚炎
衛生用品(肥皂、痱子粉)、衣物引起之接觸性皮膚炎。
6、過度流汗
肛門癢之治療
一般原則
停止搔抓。
入浴時避免使用過熱之水、避免過度之淋浴或擦洗。
浴後儘量擦乾身體,但避免用力擦拭,必要時則可使用吹風機予以吹乾。多吃蔬果保持排便順暢。避免辛辣刺激之食物(咖啡、酒、蜜餞)。
排便後使用柔軟之衛生紙予以輕輕擦拭。避免使用有刺激性之香皂及痱子粉。穿著寬鬆之衣物。避免局部塗抹藥膏除非有醫師處方。局部治療
治療引起肛門癢之病因。
避免局部麻醉劑或消毒劑(如優碘)。使用水性乳液取代肥皂。可局部使用類固醇乳膏。
臨床表現
肛周炎第二、易致皮膚濕疹:由於痔塊脫出及擴約肌鬆弛粘液流出肛門外刺激周圍皮膚,易導致騷癢及皮膚濕疹。
第三、易致肛門功能失常:由於肛門感染,肛門梳硬結、肛竇炎、肛裂、肛瘺、肛門膿腫、痔瘡等,反覆發作,經久不治,一方面導致肛門攣縮,排便困難;另一方面侵犯括約肌,易導致肛門失禁。
第四、易致敗血症、毒血症、膿毒血症、肛門膿腫、肛門感染,一但剛裂、痔瘡等出血,細菌、毒素、膿栓就易侵入血液引發敗血症,毒血症、膿毒血症。
第五、易致植物神經紊亂,可引起神經衰弱症狀,因肛門部神經與股後皮神經和坐骨神經聯繫密切,因此肛門疾患,可引起腰部,骶骨,股後部痢疼痛,還可引起泌尿生殖系統反射性技能紊亂。
第六、易引發婦科疾病:由於肛門和陰道接近,痔瘡出血或發炎往往會導致細菌大量繁殖,直入陰道,引發婦科炎症。
第七、易誘發直腸癌:痔瘡若得不到及時治療,病情不斷加重,使病區域的細胞基因發生變化導致直腸癌的產生。
第八、易導致性功能下降:痔瘺患者往往性興奮敏感下降,加之疼痛頭暈等不適刺激造成性慾下降,從而出現陽痿、早泄遺精等。
檢查
肛周炎新的治療技術則使治療可以達到前所未有的精確定位,直接針對病因進行治療,解決了以前痔瘡治療患者針對性差、創傷面積大、傷口癒合慢、併發症多,導致患者痛苦大、術後恢復不良的問題。如我院的微創消融HCPT技術,治療過程只需10分鐘,治療後24小時內患者就能正常排便,術後微痛。
而鵬程醫院採用的第二代超聲引導痔動脈電凝閉鎖系統,不需住院治療,一般只需要10-20分鐘完成治療,並可在短時間內恢復正常活動,對各種痔瘡的治癒率高達98%以上。同時,它還符合微創無痛治療的宗旨,受到廣大白領人士的追捧。傳統手術過程長,傷口癒合慢,併發症多,很難避免給患者帶來一定的痛苦。微創消融HCPT技術是一種治療痔瘡的新技術,精確度高,治療過程只需10分鐘,治療後24小時內患者就能正常排便,術後微痛。
原因
1.心理因素
肛周炎2.全身系統性疾病或皮膚病
濕疹、糖尿病、念珠菌感染、蟯蟲感染、股癬、乾癬、腹瀉造成之脫皮、抗生素之使用。
3.局部肛門直腸病變
痔瘡、肛裂、長疣。
4.過份注重肛門局部衛生
5.接觸性皮膚炎
衛生用品(肥皂、痱子粉...)、衣物引起之接觸性皮膚炎。
6.過度流汗
肛門癢之治療
原則
停止搔抓。入浴時避免使用過熱之水、避免過度之淋浴或擦洗。
浴後儘量擦乾身體,但避免用力擦拭,必要時則可使用吹風機予以吹乾。多吃蔬果保持排便順暢。避免辛辣刺激之食物(咖啡、酒、蜜餞...)。
排便後使用柔軟之衛生紙予以輕輕擦拭。
避免使用有刺激性之香皂及痱子粉。
穿著寬鬆之衣物。避免局部塗抹藥膏除非有醫師處方。
局部治療治療引起肛門癢之病因。
避免局部麻醉劑或消毒劑(如優碘)。使用水性乳液取代肥皂。可局部使用類固醇乳膏。
肛周炎導致的八大易發病症
第一、易致貧血:正常人的血色素為:男性120-160克/升;女性110-150克/升;小孩130-150克/升。男性血色素小於120克/升;女性血色素小於110克/升,即為貧血。以便血為主要症狀的痔瘺患者,往往出現貧血如果得不到及時的治療,隨著患者失血量增加會出現面色蒼白、乏力、頭昏、虛弱、記憶力下降甚至眼花、耳鳴、久坐久蹲後突然站起,可導致虛脫或暈厥。嚴重時食慾下降,腹脹下腹浮腫。
第二、易致皮膚濕疹:由於痔塊脫出及擴約肌鬆弛粘液流出肛門外刺激周圍皮膚,易導致騷癢及皮膚濕疹
第三、易致肛門功能失常:由於肛門感染,肛門梳硬結、肛竇炎、肛裂、肛瘺、肛門膿腫、痔瘡等,反覆發作,經久不治,一方面導致肛門攣縮,排便困難;另一方面侵犯括約肌,易導致肛門失禁。
第四、易致敗血症、毒血症、膿毒血症、肛門膿腫、肛門感染,一但剛裂、痔瘡等出血,細菌、毒素、膿栓就易侵入血液引發敗血症,毒血症、膿毒血症。
第五、易致植物神經紊亂,可引起神經衰弱症狀,因肛門部神經與股後皮神經和坐骨神經聯繫密切,因此肛門疾患,可引起腰部,骶骨,股後部痢疼痛,還可引起泌尿生殖系統反射性技能紊亂。
第六、易引發婦科疾病:由於肛門和陰道接近,痔瘡出血或發炎往往會導致細菌大量繁殖,直入陰道,引發婦科炎症。
第七、易誘發直腸癌:痔瘡若得不到及時治療,病情不斷加重,使病區域的細胞基因發生變化導致直腸癌的產生。
第八、易導致性功能下降:痔瘺患者往往性興奮敏感下降,加之疼痛頭暈等不適刺激造成性慾下降,從而出現陽痿、早泄遺精等。
肛周炎食療方法:
1、取玉米須適量。將玉米須燒灰存性,研為末,以香油調拌,外敷患處。
2、取樟腦丸1個,放250毫升陳醋(最好用鎮江陳醋)內浸泡3天后,用醋搽患處,1日3次,至治癒。特效。
3、用墨魚骨適量。將墨魚骨粉用火煅燒,呈棕紅色時乘熱研成細末,即成墨魚骨粉,可裝瓶待用。將患處用淡鹽水洗淨、擦乾,然後將墨魚骨粉直接撒在患處,使之形成一厚膜,最後蓋上一層油紙,外用紗布包紮,2天換1次,數次便可治癒濕疹。
防治
有些新生兒出生後一周左右,在肛門周圍甚至臀部和大腿內側會漸漸發出一塊暗紅色的斑片,斑片的邊緣稍微隆,表面經常伴有輕度脫皮,這就是由白色念珠菌引起的黴菌性肛周炎。白色念珠菌中的一種,它不僅存在於我們周圍的環境,而且在人的身上同樣常常可以發現它的蹤跡。大約有1/5孕婦的陰道中有白色念珠菌,當孩子通過產道時便有可能會受到感染。此外,在不潔的奶瓶中,這種黴菌特別容易生長,因此這也是一條重要的傳染途徑。
受感染的孩子往往一開始表現為“鵝口瘡”,這時在舌、齒齦和頰黏膜上出現一片片邊緣清楚、易碎的白色乳酪樣斑塊。念珠菌經過胃腸道達到肛門後,便可引起黴菌性肛周炎。
得了黴菌性肛周炎後,千萬不能用含有腎上腺皮質激素的油膏(如地塞米松霜、4輕鬆等),否則如同火上加油,使皮膚損害迅速擴大,而應改用克霉唑油膏,並吃一些制黴菌素和複合維生素B藥片。凡是孩子用過的奶瓶,洗淨後都要煮過,橡皮奶頭要洗淨再用開水燙,然後放在太陽下曝曬,孩子的腳布要與大人分開,只有這樣才能徹底治好“黴菌性肛周炎”。